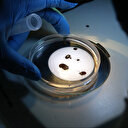
Türkiye'de yeni bir kene türü keşfedildi: 30'dan fazla hastalık taşıyabiliyor

Tokat'ta sürücüsünün direksiyon hakimiyetini kaybetmesi sonucu bir marketin önünde bulunan palete çarpan otomobil tarlaya savruldu. Kazada bir kişi yaralandı.
Tokat'ın Zile ilçesinde market önündeki palete çarpan otomobilin tarlaya savrulduğu kazada 1 kişi yaralandı.
Edinilen bilgilere göre, Zile yönünden Turhal istikametine seyir halinde olan A.E. yönetimindeki 60 AGZ 898 plakalı otomobil, Zile-Turhal Karayolu'nun 3. kilometresinde sürücüsünün direksiyon hakimiyetini kaybetmesi sonucu yol kenarındaki bir marketin önünde bulunan palete çarptı. Çarpmanın etkisiyle otomobil takla atarak tarlaya savruldu. İhbar üzerine olay yerine sağlık ve polis ekipleri sevk edildi. Zile Devlet Hastanesine kaldırılan A.E.'nin sağlık durumunun iyi olduğu öğrenildi. Kazayla ilgili inceleme başlatıldı.